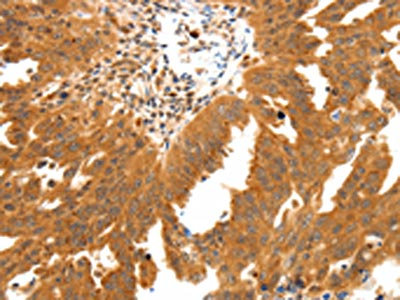

SSTR2 Antibody
-
中文名稱:SSTR2兔多克隆抗體
-
貨號:CSB-PA260413
-
規格:¥1100
-
圖片:
-
The image on the left is immunohistochemistry of paraffin-embedded Human ovarian cancer tissue using CSB-PA260413(SSTR2 Antibody) at dilution 1/30, on the right is treated with synthetic peptide. (Original magnification: ×200)
-
Gel: 10%SDS-PAGE, Lysate: 60 μg, Lane: Mouse thymus tissue, Primary antibody: CSB-PA260413(SSTR2 Antibody) at dilution 1/350, Secondary antibody: Goat anti rabbit IgG at 1/8000 dilution, Exposure time: 1 minute
-
-
其他:
產品詳情
-
Uniprot No.:
-
基因名:
-
別名:SSTR2; Somatostatin receptor type 2; SS-2-R; SS2-R; SS2R; SRIF-1
-
宿主:Rabbit
-
反應種屬:Human,Mouse,Rat
-
免疫原:Synthetic peptide of Human SSTR2
-
免疫原種屬:Homo sapiens (Human)
-
標記方式:Non-conjugated
-
抗體亞型:IgG
-
純化方式:Antigen affinity purification
-
濃度:It differs from different batches. Please contact us to confirm it.
-
保存緩沖液:-20°C, pH7.4 PBS, 0.05% NaN3, 40% Glycerol
-
產品提供形式:Liquid
-
應用范圍:ELISA,WB,IHC
-
推薦稀釋比:
Application Recommended Dilution ELISA 1:1000-1:5000 WB 1:200-1:1000 IHC 1:50-1:200 -
Protocols:
-
儲存條件:Upon receipt, store at -20°C or -80°C. Avoid repeated freeze.
-
貨期:Basically, we can dispatch the products out in 1-3 working days after receiving your orders. Delivery time maybe differs from different purchasing way or location, please kindly consult your local distributors for specific delivery time.
-
用途:For Research Use Only. Not for use in diagnostic or therapeutic procedures.
相關產品
靶點詳情
-
功能:Receptor for somatostatin-14 and -28. This receptor is coupled via pertussis toxin sensitive G proteins to inhibition of adenylyl cyclase. In addition it stimulates phosphotyrosine phosphatase and PLC via pertussis toxin insensitive as well as sensitive G proteins. Inhibits calcium entry by suppressing voltage-dependent calcium channels. Acts as the functionally dominant somatostatin receptor in pancreatic alpha- and beta-cells where it mediates the inhibitory effect of somatostatin-14 on hormone secretion. Inhibits cell growth through enhancement of MAPK1 and MAPK2 phosphorylation and subsequent up-regulation of CDKN1B. Stimulates neuronal migration and axon outgrowth and may participate in neuron development and maturation during brain development. Mediates negative regulation of insulin receptor signaling through PTPN6. Inactivates SSTR3 receptor function following heterodimerization.
-
基因功能參考文獻:
- SSTR2A expression is infrequent in astrocytomas and negative in the majority of glioblastomas where it is of no prognostic significance. In contrast, oligodendrogliomas show intense membranous and cytoplasmic SSTR2A expression. PMID: 28467778
- The results of this study showed the SSTR2 expression was lower in patients pretreated with LA-SSA/PEGV compared to the drug-naive acromegalic patients. PMID: 27455094
- IHC of SSTR subtypes in the different cohorts showed SSTR2 staining intensity scores higher than SSTR5 in TSHoma, acromegaly and prolactinoma, whereas the expression of SSTR5 was stronger than SSTR2 in corticotropinoma and NFPA. PMID: 28434012
- SSTR2 was significantly hypermethylated in colorectal cancer tissues when compared with adjacent normal colorectal tissues. PMID: 28782576
- This study investigated the presence of progenitor/stem cells in non-functioning pituitary tumors (NFPTs) and tested the efficacy of dopamine receptor type 2 (DRD2) and somatostatin receptor type 2 (SSTR2) agonists to inhibit in vitro proliferation PMID: 28120505
- expression of MDM2, somatostatin receptor 2A, and PD-L1 in follicular dendritic cell sarcoma PMID: 27402219
- Combination treatment increased both SSTR2 and SSTR5 mRNA and protein levels in DU-145 cells. The data suggest that this combination therapy may be a good candidate for patients with advanced metastatic Prostate cancer (PCa) do not respond to androgen deprivation. PMID: 26531719
- although the limited number of cases with adequate term follow-up, SSTR-2A expression could be a prognostic factor and somatostatin analogs therapeutic candidate for SmCCs of the bladder as these tumors show high percentage of SSTR-2A expression PMID: 25906124
- SSTR2 expression was tested in GH-secreting adenomas from 60 patients with acromegaly who had undergone pituitary surgery, 36 of whom had received octreotide with varying levels of response. Its expression was not correlated with baseline or post-octreotide GH or IGF-1 levels or tumor volume. PMID: 25008035
- Filamin-A is required to mediate SSTR2 effects in pancreatic neuroendocrine tumours PMID: 26733502
- SSTR2 promoter hypermethylation might be associated with the risk and progression of laryngeal squamous cell carcinoma in males. PMID: 26796520
- VPA was observed to stimulate the expression of somatostatin receptor type 2 (SSTR2). PMID: 26211366
- Results show that histological subtyping of pituitary tumor correlated with SSTR2, E cadherin and p27kip protein levels and these may serve as useful biomarkers for prognosis. PMID: 26391562
- there is an elevation in CXCR4 and a decrease in SSTR2A expression with increasing malignancy in gastroenteropancreatic neuroendocrine neoplasms PMID: 26259237
- mir-185 regulates the expression of SSTR2 in GH-secreting pituitary adenoma. The staining intensity of SSTR2 is stronger in adenoma samples than controls. PMID: 26036598
- Data indicate that somatostatin receptor scintigraphy (SRS) and immunohistochemical results for somatostatin and dopamine receptors sstr2, sstr3, sstr5 and D2R were compared in neuroendocrine neoplasms tissues. PMID: 25808161
- CD56 marker is a useful alternative that is comparable to SSTR2A for the diagnosis of phosphaturic mesenchymal tumors. PMID: 26339384
- The number of SSTR-2-expressing cells was significantly smaller in the patients with Crohn's disease than that in those with the unchanged mucosa and in those with indeterminate (unclassified) colitis. PMID: 26978232
- In pancreatic neuroendocrine tumors, the primary tumor and metastases differ significantly in their SSTR2A expression. PMID: 25872131
- Study demonstrates the first evidence of SST2R expression and somatostatin receptor scintigraphy positivity in pancreatic serous cystadenomas. PMID: 25872132
- Somatostatin receptors were expressed in a high proportion of merkel cell carcinomas, although expression was heterogeneous between tumours and was not associated with disease severity. PMID: 25765179
- SSTR2 gene expression was dysregulated in the anterior cingulate of bipolar patients. PMID: 26238605
- Low SSTR2 expression is associated with pancreatic cancer. PMID: 25890201
- e hSSTr2 gene can act as not only a reporter gene for in vivo imaging, but also a therapeutic gene for local radionuclide therapy. PMID: 25879040
- Somatostatin type 2 receptor, a clinically crucial molecular target, shows variable and unpredictable expression in neuroendocrine neoplasms irrespective of tumor grade. PMID: 25591947
- This study indicated that SSTR2 may be associated with the selective vulnerability of the noradrenergic system in Alzheimer's disease. PMID: 25676386
- sST2 is proposed as a biomarker for progressive vascular fibrosis, and the involvement of sST2 in the pathogenesis of limited cutaneous systemic sclerosis may be exploited therapeutically. PMID: 26095613
- The expression of VEGF and SSTR2 were associated with progression and prognosis of gastric cancer. PMID: 26158180
- SSTR2 and SSTR5 protein levels were induced as compared to any agent alone. PMID: 25925002
- SSTR 5 was shown to be the main receptor subtype in the analysed differentiated or anaplastic thyroid malignancies, whereas SSTR 2 was found only in a small percentage. PMID: 24967740
- SSTR2A and SSTR3 are more likely to be expressed in SDH-deficient pheochromocytomas/paragangliomas compared with tumors demonstrating normal SDHB staining pattern. PMID: 25554089
- Relationships between SSTR2A and breast or prostate cancer showed low concordance between CpGs methylation grade and cancer. PMID: 25635370
- SSTR2 expression seems an important factor in the pathogenesis of prostate cancer PMID: 25010045
- agonist-selective sst2 receptor internalization is regulated by multi-site phosphorylation of its carboxyl-terminal tail. PMID: 24565897
- Filamin A is involved in SST2 stabilization and signaling in tumoral somatotrophs, playing both a structural and functional role. PMID: 24828612
- SSTR2 is overexpressed in gastric and duodenal neuroendocrine tumors PMID: 24565507
- We genotyped two single nucleotide polymorphisms (SNPs) in genes of importance for respiratory control: P2RY1 (adenosine diphosphate/adenosine triphosphate receptor) and SSTR2 (somatostatin receptor). PMID: 23828624
- ZAC1 and SSTR2 are down-regulated in non-functioning pituitary adenomas but not in somatotropinomas. PMID: 24098585
- Whereas sst2 receptors might play a primary role in the differentiation and regulation of TSH, LH, and FSH cells, sst5 receptors appear to be mainly involved in GH regulation from birth onward PMID: 24189142
- The analyses of this study demonstrated specific upregulation of sst 2 mRNA in medulloblastoma PMID: 23677175
- We studied the expression of SSTR(2A) and SSTR(5) with new procedures in 108 pituitary tumors PMID: 24182563
- Somatostatin receptor-2 positivity, either focal or diffuse, does not seem to predict prognosis in gastroenteropancreatic neuroendocrine tumors. PMID: 23794313
- Because of its diffuse strong expression and widespread availability, immunohistochemistry for SSTR2A is useful to confirm the diagnosis of phosphaturic mesenchymal tumors in an appropriate setting particularly if material is limited. PMID: 24060005
- mRNA levels of SSTR2a, SSTR3 and SSTR5 in neuroendocrine lung cancer affected patients, were determined. PMID: 21503779
- Low somatostatin receptor subtype 2, but not dopamine receptor subtype 2 expression is associated with the lack of biochemical response of somatotropinomas to treatment with somatostatin analogs PMID: 22472799
- Results suggest that targeting adenoviral vectors to sstr2A could provide a new strategy for the efficient transfer of genes to glioblastoma cells. PMID: 22592599
- Report down-regulation of SSTR-2 expression in operable hepatocellular carcinomas. PMID: 22640914
- Data suggest that somatostatin-14 inhibits secretion from alpha and beta pancreatic cells by activating GIRK (G protein-coupled inwardly-rectifying potassium channel) and inhibiting exocytosis; these effects are mediated by SSTR2 in both cell types. PMID: 22932785
- Mean cortical SSTR2 mRNA levels were significantly (19%) lower in the subjects with schizophrenia compared to controls. PMID: 21215273
- Data show that the aspartic acid changes at position 89 to either Ala, Leu, or Arg generated mutant somatostatin receptor subtype 2 (SSTR2) with varying expression profiles and a complete inability to bind somatostatin-14 (SST). PMID: 22495673
顯示更多
收起更多
-
亞細胞定位:Cell membrane; Multi-pass membrane protein. Cytoplasm. Note=Located mainly at the cell surface under basal conditions. Agonist stimulation results in internalization to the cytoplasm.
-
蛋白家族:G-protein coupled receptor 1 family
-
組織特異性:Expressed in both pancreatic alpha- and beta-cells (at protein level). Expressed at higher levels in the pancreas than other somatostatin receptors. Also expressed in the cerebrum and kidney and, in lesser amounts, in the jejunum, colon and liver. In the
-
數據庫鏈接:
Most popular with customers
-
-
YWHAB Recombinant Monoclonal Antibody
Applications: ELISA, WB, IHC, IF, FC
Species Reactivity: Human, Mouse, Rat
-
Phospho-YAP1 (S127) Recombinant Monoclonal Antibody
Applications: ELISA, WB, IHC
Species Reactivity: Human
-
-
-
-
-